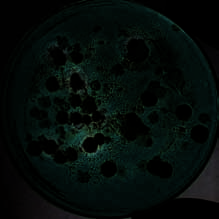
index-79_1.jpg

AND PREVENTION
is sensitive to chloroquine
Us vs. Them
So why don’t they kill human cells, too? The
Many scientists focus on human genes, most of
answer is that human and bacterial ribosomes are
which have counterparts in the genomes of
different. Genome sequencing is a powerful tool
model organisms. However, in the case of infecfor identifying differences that might be promistions caused by microorganisms, understanding ing targets for new drugs.
how the genomes of bacteria, viruses and para
Comparing genetic sequences in organisms
sites differ from ours is a very important area of
that are resistant and nonresistant to drugs can
health research.
reveal new approaches to fighting resistance.
Most of the medicines we take to treat infec
Drug resistance is a worldwide problem for a
tions by bacteria and viruses have come from
number of diseases, including malaria.
scientists’ search for molecular weak points in
Although researchers have developed several
these tiny organisms. As mentioned in Chapter 1,
different types of medicines to treat this disfor example, some antibiotics kill bacteria by ease — caused by parasites carried by mosquitoes,
disarming their proteinmaking ribosomes.
not by a bacterium or a virus — malaria is rampant, especially in the developing world.


The New Genetics I Genes Are Us 69
GENETICS AND YOU: Eat Less, Live Longer?
Would you consume an ex that by restricting the
tremely lowcalorie diet if it
formation of extra DNA,
meant you would live longer?
sirtuins keep the yeast
The kind of diet we’re talking about
young.
isn’t just cutting back here and there. It
Not so fast, say other
involves severely reducing calorie intake
scientists like geneticist
to about 60 percent of what we nor
Stanley Fields of the
mally eat, enough to make most people
University of Washington. His experiments
ravenously hungry.
have turned up other, unrelated genes
A 19thcentury French doctor,
linked to lifespan in yeast. He argues that
Maurice Gueniot, thought the tradeoff
while calorie restriction is the only interwould be worth it. Throughout his adult vention that has been shown to extend
life, he ate very little. He died at the ripe
lifespan in a wide range of organisms,
old age of 102!
including mammals, the accumulation of
Later, in the 1930s, researchers
extra DNA does not always appear to play
followed up on this observation by
a role in this process.
showing that rats on a diet containing
What’s the final answer, you ask? It’s
20 percent indigestible fiber— calories
probably a bit of both.
that can’t be used — lived much longer
Molecules like sirtuins, which are
than their normally fed peers.
involved in cellular metabolism, may pro
Intrigued by the health connection,
tect cells against the harmful effects of
scientists are continuing to investigate
stress, extending lifespan. Other molepotential links between diet and aging, cules that affect different aspects of cell
and genetic studies are starting to turn
health may be just as important.
up some clues.
Lifespan in complex, multicellular
For example, geneticist David Sinclair
organisms like people is affected by many
of Harvard Medical School has found that
different factors, most of which we know
proteins known as sirtuins may be able to
very little about. For sure, understanding
stall aging. As yeast cells age, they accumore about these mystery molecules mulate extra DNA, which eventually kills
could have a considerable benefit—
them. Sinclair discovered that sirtuins
perhaps providing you a chance to add
become more active in yeast cells that
years to your life without starving!
are on a lownutrient “diet.” He reasons


70 National Institute of General Medical Sciences This is partly
Gang Warfare
because not all people
Did you know that scientists are using genetics to
have access to treatbreak up gangs … of microbes, that is? These ment, or to simple
gangs, known as biofilms, are layers of slime that preventive measures like
develop naturally when bacteria congregate on
bed nets, which protect
surfaces like stone, metal and wood. Or on your
sleeping people from
teeth: yuck!
GATHANY
ES
Biofilms grow in all sorts of conditions. For
JAM
mosquito bites. But
C/
CD
another problem is the
example, one biofilm known as “desert varnish”
Mosquitoes spread
malaria parasite itself, which has rapidly evolved
thrives on rocks, canyon walls or, sometimes,
malaria by picking up
parasites from blood and
ways to avoid the effects of antimalarial drugs.
entire mountain ranges, leaving a reddish or
spreading them to the
next person they bite.
Scientists are trying to counter this process by
othercolored stain. It is thought that petroglyphs
Resistance spreads this
way, too.
studying microbial genetic information. In the
left on boulders and cave walls by early desert
case of malaria, geneticists like Dyann Wirth of
dwellers were often formed by scraping through
the Harvard School of Public Health compare the
the coating of desert varnish formations with a
genomes of drugresistant parasites and those
hard object.
that can still be killed by antimalarial medicines.
Sometimes, biofilms perform helpful func
Wirth’s research suggests that it should be
tions. One of the best examples of the use of
possible to develop a simple, inexpensive genetic
biofilms to solve an important problem is in the
test that could be given to people with malaria,
cleaning of wastewater.
anywhere in the world. This test would identify
drugs that are likely to be most effective
and help decrease the rate at which
parasites become resistant to the antimalarial medicines we already have.
Biofilms, like the one shown in this
P.
SINGH
fluorescent microscopic photo, are
bacterial communities.
AND
E.
PETER
GREENBERG

The New Genetics I Genes Are Us 71
Bonnie Bassler (right)
uses glowinthe dark
bacteria to study
the genetics of biofilms.
DENISE
APPLEWHITE
But biofilms can be quite harmful, congoal of being able to use this knowledge to break tributing to a wide range of serious health
up bacterial “gang meetings.”
problems including cholera, tuberculosis, cystic
Bassler’s research subjects have a definite
fibrosis and food poisoning. They also underlie
visual appeal. They glow in the dark, but only
many conditions that are not lifethreatening
when they are part of a group. The bioluminesbut are nonetheless troublesome, like tooth cence, as the glow is called, arises from chemical
decay and ear infections.
reactions taking place within the biofilm. It pro
Bacteria form biofilms as a survival measure.
vides a way for the bacteria to talk to each other,
By living in big groups rather than in isolation,
estimate the population size of their community
the organisms are able to share nutrients and
and distinguish themselves from other types of
conserve energy. How do they do it?
microorganisms.
A biofilm is not just a loose clump of cells —
Through her studies, Bassler has identified a
it’s a highly sophisticated structure. As in any
set of molecules that biofilmforming microorcommunity, the individuals in biofilms commuganisms use to pass messages to each other. By nicate with each other.
devising genetically based methods to cut off
Beyond that, many aspects of biofilms are
the chatter, Bassler reasons, she may be able to
poorly understood. Bacterial geneticist Bonnie
cause bacterial communities to fall apart. This
Bassler of Princeton University in New Jersey is
approach would provide a whole new way to treat
working to understand biofilms better, with the
health problems linked to harmful biofilms.

72 National Institute of General Medical Sciences The Tools of Genetics: Mathematics and Medicine What if public health officials had a script for
Since 2005, the Models of Infectious Disease
what to do in the face of an infectious disease
Agent Study (MIDAS), a team of biologists, comoutbreak that had never been seen before? One puter scientists, statisticians, mathematicians,
thing that would help them prepare for this sort
social scientists and others, has been modeling
of scenario is the ability to know, ahead of time,
a flu pandemic—a huge, global epidemic.
how an epidemic develops and spreads.
Initially, the models focused on avian
Toward this goal, some scientists are using
influenza, a type of disease occurring naturally
mathematical tools to create simulations, or
among wild birds. At the time, health experts
models, of infectious disease outbreaks. They
worldwide worried that the virus’ genetic matecan then use the models to test the effects of rial could mutate, making it much easier for the
various intervention strategies. Part of the work
socalled “bird flu” to pass between humans.
involves plugging in genetic information about
To simulate the potential disease spread, the
how infectious organisms evolve over time
scientists wrote computer programs that incorpoand how fast they change as they interact with rated information about the bird flu virus and
human populations.
actual communities. Including details about
people—not just their ages and genders, but
also where they live, work or go to school—let
the researchers create a synthetic population that
could mirror how a real one might get sick and
spread disease.
The scientists ran the programs on large
computers to see how the flu could spread with
and without different interventions. The results
indicated that to successfully contain an epidemic,
health officials would need to find the first flu
cases fast and implement a combination of public
health measures very quickly.
Computer simulations are helping scientists understand how infectious diseases spread.


Got It?
Discuss how mathematics
can help scientists ask questions about human health.
Would you contribute a
sample of your DNA for
genetic research on common
This early work helped MIDAS scientists
During both the bird and swine flu modeldiseases like heart disease, develop similar models of H1N1 or “swine flu,”
ing efforts, the MIDAS scientists worked
depression or cancer—
the first actual pandemic flu strain since 1968.
closely with public health officials to address
even if you didn’t have any
Starting in April 2009, they gathered incoming
specific questions. The answers informed U.S.
of these health problems?
public health data to simulate the potential
pandemic flu preparedness planning.
Why or why not?
spread of this global flu, identify the groups most
Influenza, however, is not the only infeclikely to get sick and evaluate the usefulness of tious disease making people sick. MIDAS
different public health measures, such as vaccinascientists are also modeling other major health Drugs work like they’re
tion and quarantine. Their models suggested that
threats, including cholera, dengue fever,
supposed to in only half the
vaccinating schoolchildren early in an outbreak
malaria, tuberculosis and methicillinresistant
people who take them, so
could reduce overall disease spread and that
Staphylococcus aureus (MRSA).
scientists are trying to make
people at risk of serious complications should
“personalized medicines” that
be given antiviral medications to take at the
work very well in an individfirst signs of illness.
ual because they match his
or her genetic makeup. Are
there economic, social or
other issues that the development of such medicines
might raise?

C H A P T E R 5
21stCentury Genetics
Medicine has evolved tremendously since practices like opening the vein of a sick person the earliest human civilizations, when
and draining off quarts of precious blood!
the diagnosis and treatment of disease were far
Later, in the Renaissance period of the 15th
from scientific. Medieval medicine, for example,
and 16th centuries, scholars centered on anatomy.
relied heavily on supernatural beliefs. Limited
One of them, the Italian artistinventor Leonardo
scientific knowledge led to seemingly bizarre
da Vinci, created beautiful and accurate
RARE
BOOK
AND
SPECIAL
COLLECTIONS
DIVISION,
LIBRARY
By the end of the 16th
century, anatomy was a
OF
common focus for scien
CONGRESS
tific scholars.

The New Genetics I 21stCentury Genetics 75
19thcentury scientists
illustrations of the human body. His work
discover ed that bacteria
and that of other scientists of his day
can cause disease. Bacillus
anthracis (left) causes anthrax
focused on the practice of dissection,
and Vibrio cholerae (below)
causes cholera.
providing neverbeforeseen details of
PAUL KEIM (ANTHRAX),
the body’s architecture of limbs, joints,
CDC/ WILLIAM A. CLARK (CHOLERA)
muscles, nerves and vessels.
Modern medicine got its real start
during the 19th century, after the microscope was invented. Medical school subjects like physiology, pathology and microbiology were
born. During this time, scientists discovered that
bacteria — not evil spirits or other imaginary
One of today’s challenges is to map the
entities — caused human diseases like cholera,
actions and interactions of all these molecules,
anthrax and tuberculosis.
a focus of the new field called systems
The birth of modern genetics, which
biology. Genetic and genomic
occurred in the 20th century, accelerated the
research is helping scienstudy of all these areas of science. Now, at tists tackle many
the start of the 21st century, opportunities
questions in this
have never been greater for turning scientific
area. By building
knowledge into better health for all.
models of cells,
We often take for granted the amazing
tissues and
complexity of the human body. Without even
organs in action,
thinking, we sweat to maintain body temperascientists hope to ture, get hungry when we need energy and feel
learn how these
tired when we need to sleep.
complex, dynamic
These seemingly simple actions require a
systems work.
sophisticated coordination of many different
Researchers need to know
organs and the millions of molecules that work
these basics in order to understand how the
together inside them. Thousands of networks
systems fail, when disease strikes. An essential
of interacting genes underlie these actions in
tool in this research is the computer.
our bodies. But these systems are proving to
have far more fluctuation than scientists
originally suspected.


76 National Institute of General Medical Sciences No Lab? No Problem!
Those who work at the intersection
of computer science and biology
often combine and analyze data
from many different sources, looking for informative patterns.
Andrey Rzhetsky of the
University of Chicago is one
of these people. Through an
approach known as knowledge
engineering, Rzhetsky and his team
write computer programs that scan the contents
The program first scans scientific papers
of thousands of published scientific papers.
using preset search terms, much like a Google™
The “knowledge mining” tool they use, called
search of the Web. Next, it evaluates the search
GeneWays, focuses mainly on research literature
results and makes sure they don’t overlap. For
about changes in genes and proteins.
example, if a molecule has 16 different names
in different papers, the program simplifies it to
just one.
Green Fluorescent Protein
Here’s an interesting news
Called green fluorescent protein, or GFP, this
flash: “Glowinthedark
natural protein is found in specific parts of the
jellyfish revolutionizes
jellyfish. Those parts glow because the protein
genetic research! ”
absorbs energy from light in the environment
COYNE
Although it may sound
and then produces a different color of light.
bizarre, the claim is true.
Scientists don’t really know how and why jelly
JERRY
AND
A jellyfish protein is
fish use their glow. They do know that jellyfish
EZ
essential to modern
don’t flash at each other in the dark, nor do they
ERNANDF
cell biology experiments
glow continuously. And the glow is rarely seen in
that track the movements,
undisturbed animals.
CATHERINE
quantities and interactions
Taken out of the jellyfish, GFP has played a
. Fruit fly sperm cells glow bright green when they of the millions of proteins
major role in advancing the study of genes and
express the gene for green fluorescent protein.
inside cells.
the proteins they encode. The story of how GFP


The New Genetics I 21stCentury Genetics 77
Finally, after applying specific rules, sort of
like “biological grammar,” the computer program
identifies associations, which are possible links
between molecules. The information then goes to
a database that Rzhetsky and other scientists use
to build large networks of molecular interactions.
Rzhetsky and his team used GeneWays to identify risk genes for Alzheimer’s disease, a complex condition thought to be caused by many factors.
In analyzing the data, Rzhetsky found important
“nodes,” molecules that play key roles in the disease gene network that GeneWays modeled.
These predicted molecular interactions were
AND
REY
later confirmed by other researchers working in a
RZHETSKY
lab, underscoring the value of computer model
AND
ing as a way to learn more about the molecular
KEVIN
P.
basis of disease.
WHITE
. Andrey Rzhetsky uses the computer program
GeneWays to locate important “hubs” of activity
(large spheres) within massive gene networks.
This particular network represents embryonic
developmental pathways in a fruit fly.
became a research tool began in 1992, when
used the GFP gene to create greenglowing
Martin Chalfie of Columbia University showed
zebrafish. Although the fish were created for
that the gene that makes GFP produced a fluoresthe purpose of scientific research, they’ve cent protein when it was removed from the
also become an “exotic” species for home
M
jellyfish genome and transferred to the cells of
aquariums.
ARTIN
other organisms (see page 38). Chalfie, a devel
Thanks to GFP and related technologies,
CHALF
opmental biologist, first put the gene into
scientists can now view living cells and their
IE
bacteria and roundworms, creating glowing
constantly moving contents. GFP is also used
. Scientists engineered
versions of these animals.
in diagnostic tests for drugs, foods, herbicides
this experimental worm
Since then, researchers have transferred the
and hazardous chemicals.